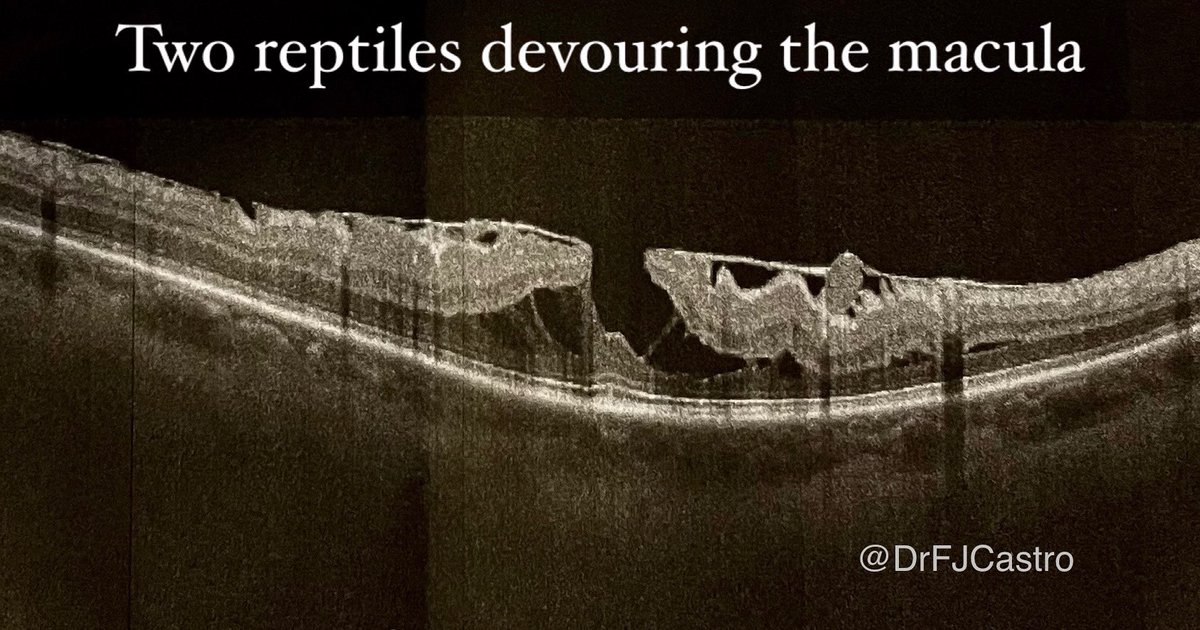
Can you imagine it? “Two reptiles devouring the macula”

Eres capaz de imaginártelo? “Dos reptiles devorando la mácula”

#oct #macula #ophthalmology #oftalmologo #drfjcastro

Francisco J. Castro
@fjcastromd
Oftalmólogo. Doctor en Medicina. Ophthalmologist, MD PhD. Hospital de Alcañiz. Clínica de Oftalmología Dr FJ Castro. Investigador. Instagram 📸 @fjcastroalonso
ID: 1194020428131508224
11-11-2019 22:34:03
485 Tweet
230 Followers
167 Following












Apúntate gratis en academia-retina.teachable.com y descubre las actualizaciones de un EXPERTO en Biometría AVANZADA como el Dr Francisco J. Castro




Primer implante de la LENTE INTRAOCULAR “EnVista Aspire” en España para pacientes con cataratas… Dr Francisco J. Castro, #HUMS #UFR #Zaragoza Bausch + Lomb España Bausch + Lomb #aragon #cararact #ophthalmology linkedin.com/posts/francisc…